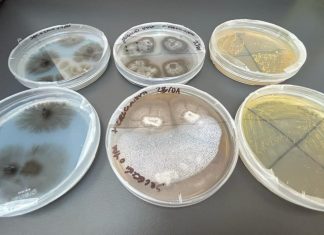
Universidad de Valparaíso inaugura Laboratorio de Biotecnología

Seremi Cofré: «No tenemos casos autóctonos de Dengue»
Existe preocupación en la autoridad de salud, pues el mosquito vector del dengue ha provocado verdaderos dolores de cabeza en los países fronterizos. Sólo...
Buscan proteger Parque Juncal de amenaza minera
La realización de un proyecto minero de la empresa norteamericana Nutrex SpA, tiene en alerta máxima a medioambientalistas, tras la adquisición de 15 pertenencias...
San Felipe por fin cuenta con su PLADECO
Este martes fue entregado oficialmente a la Alcaldesa Carmen Castillo, miembros del Concejo Municipal y Directores Municipales, el Plan de Desarrollo Comunal, PLADECO 2023-2030,...
Municipalidad pagará furgón destruido por caída de rama
Pasadas las ocho y media de la mañana de este lunes, Matías Chacón llegó al taller mecánico que su familia tiene en la Avenida...
Falso Sacerdote celebra matrimonio en San Felipe
Las redes sociales no dejan pasar una. Y es que la viralización de un matrimonio realizado en la Parroquia Andacollo, permitió confirmar que dicho...
Positivo balance en primer aniversario de Delegación de Curimón
En el Centro Comunitario "Profesor Luis Blanca Tello" se celebró el primer año de funcionamiento de la Delegación Municipal.
Liderada por el Abogado José Luis...
Comenzó Censo 2024
Con ceremonias en todo el país, y autoridades desplegadas en terreno, comenzó la ejecución del Censo de población y de vivienda.
A nivel local, lo...
Gobierno Regional da continuidad a programa Proempleo
2.165 mujeres serán beneficiadas, gracias a la continuidad hasta diciembre de 2024 del programa Proempleo, iniciativa priorizada por el Gobernador Regional Rodrigo Mundaca Cabrera,...
Los Andes: Postergan inicio de año escolar en Liceo
La Directora de Educación Municipal, María Soledad Reinoso, informó que las clases en el emblemático Liceo Maximiliano Salas Marchan, comenzarán el lunes 11 de...
Incautan nuevo «pelotazo» en Cárcel de Los Andes
El lanzamiento, conocido popularmente como “pelotazo”, llevaba en su interior municiones y hojas de sierra, que iban dirigidos al interno de iniciales P.C.G.
Esto ocurrió...
San Felipe: ya se puede postular a subvenciones sociales
La Municipalidad de San Felipe ya abrió la postulación para las diversas organizaciones sociales de la comuna. Éstas deben formular proyectos que les permitan...
Universidad de Valparaíso inaugura Laboratorio de Biotecnología
Como un gran avance, para el área de la investigación en el Valle de Aconcagua, fue recibido el nuevo Laboratorio de Biotecnología del Campus...